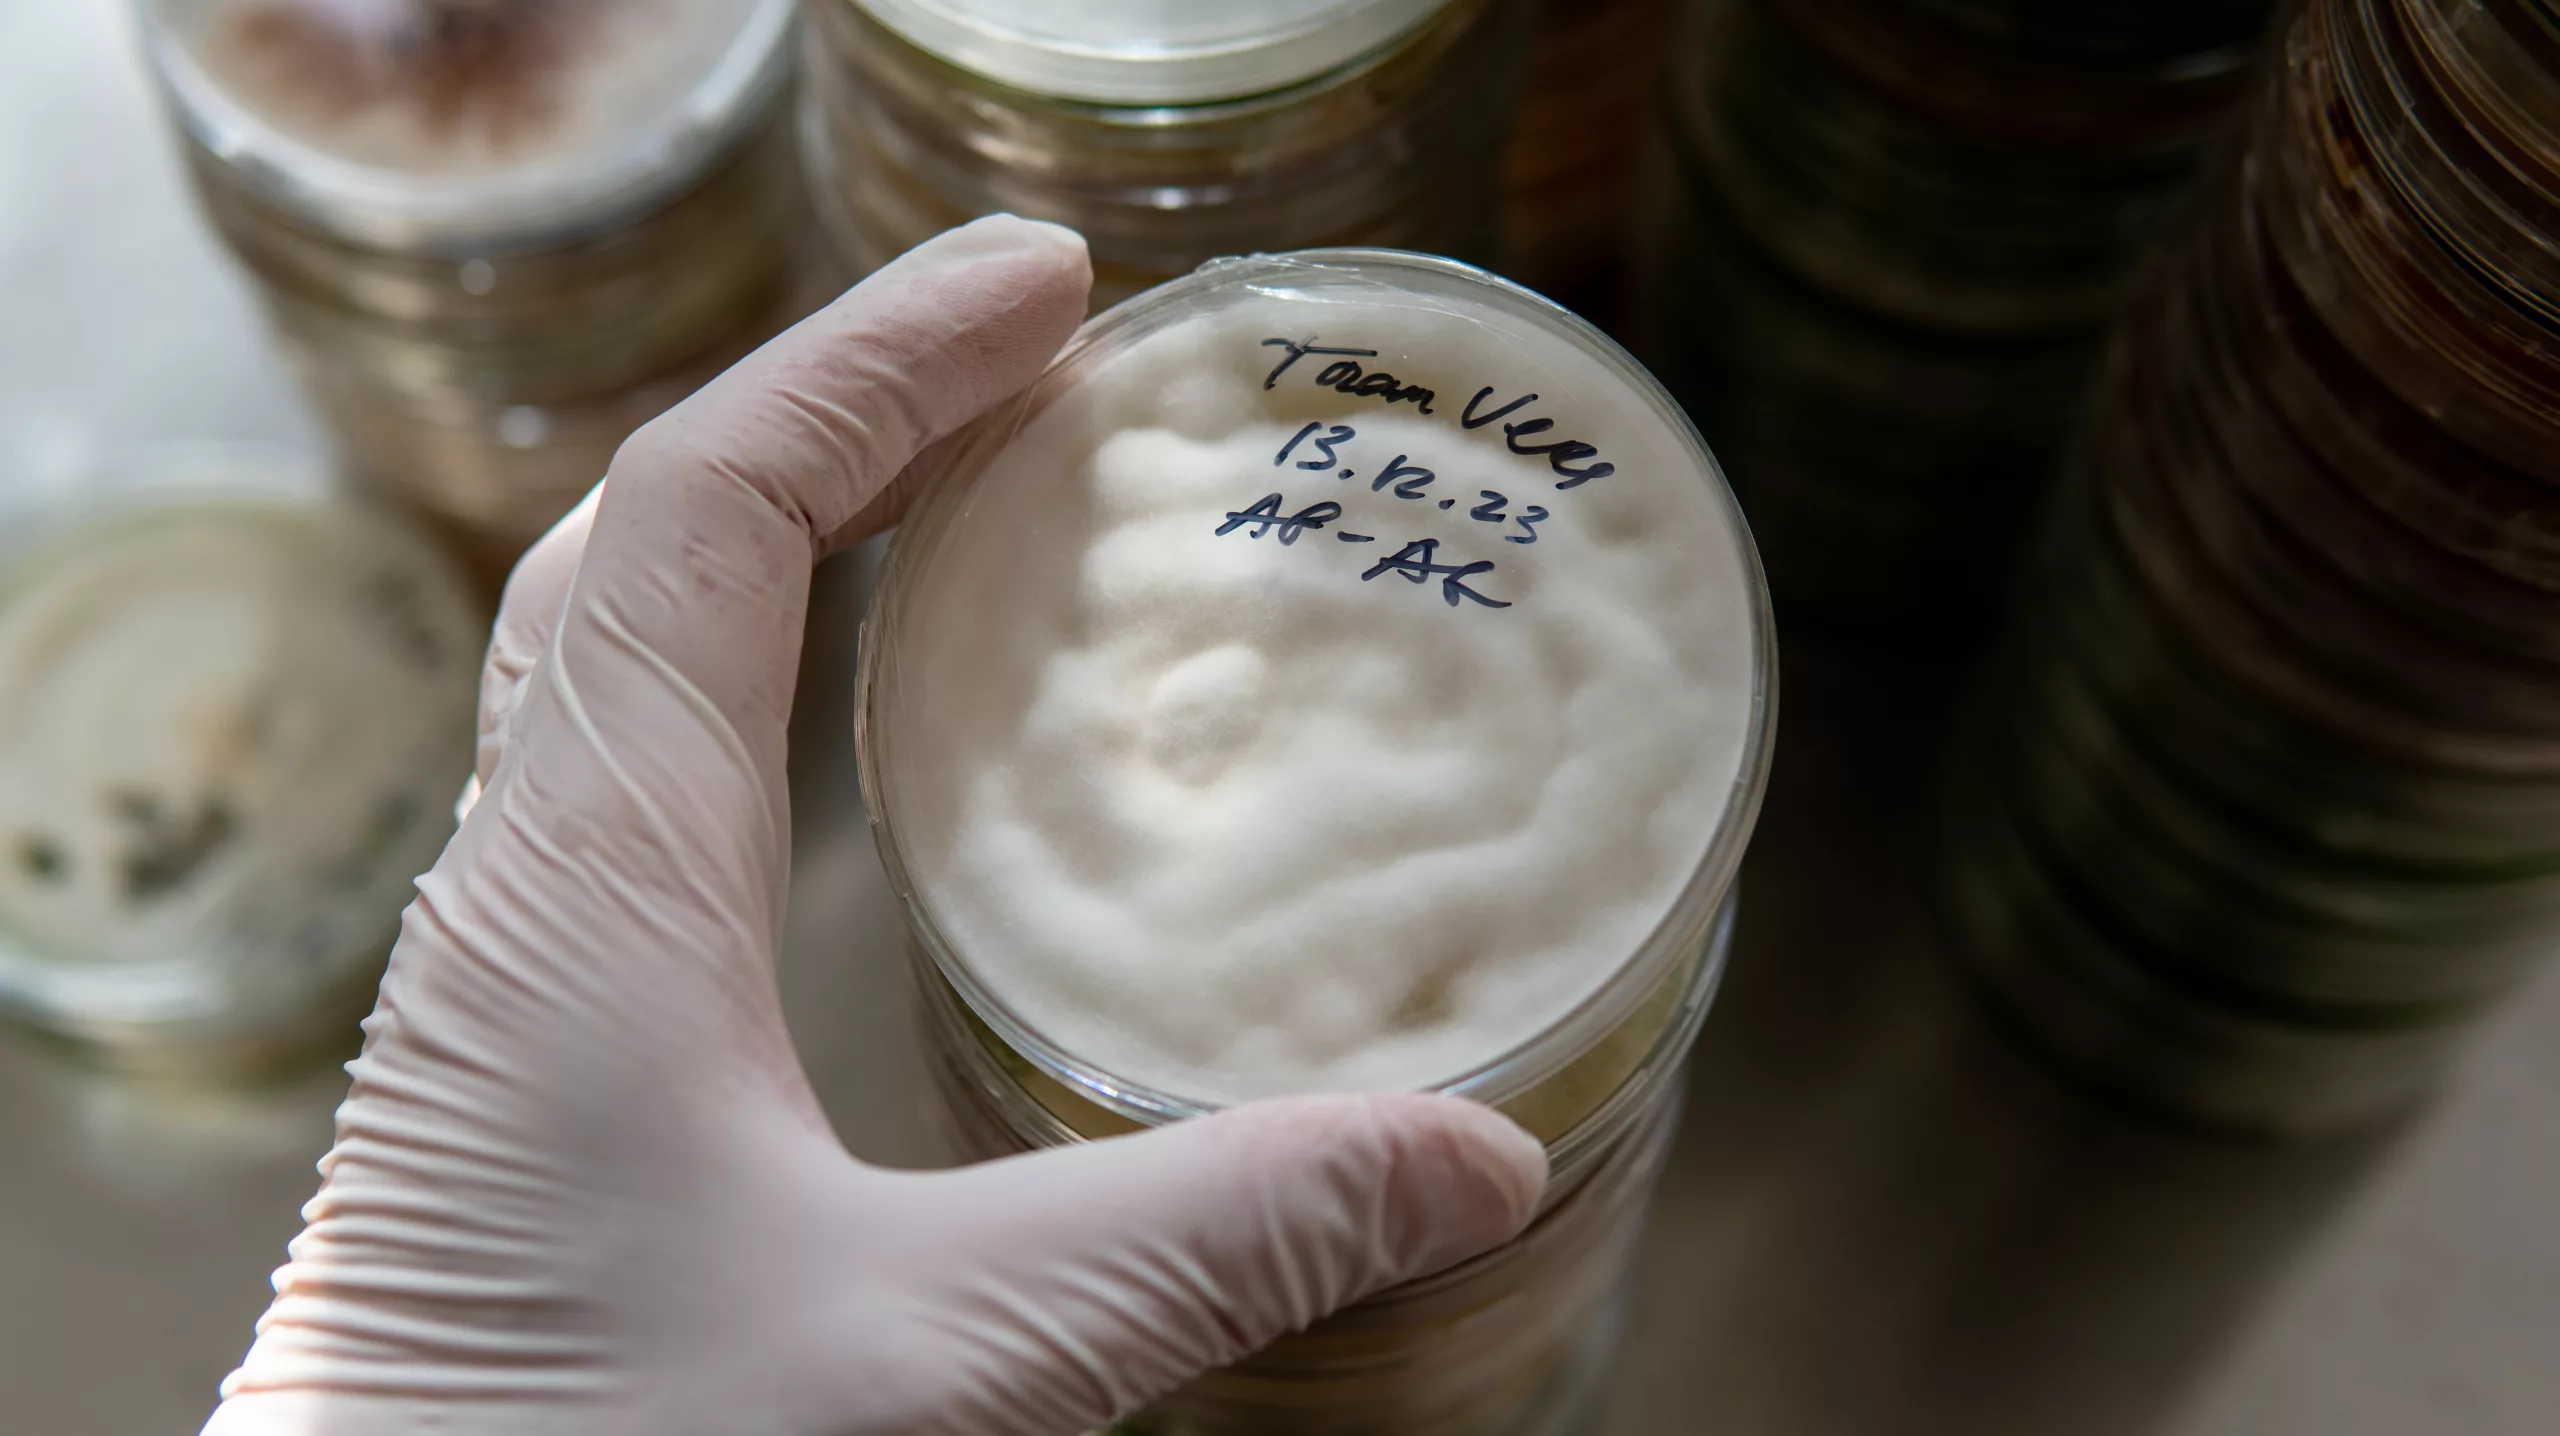

In dieser ersten Phase werden unter kontrollierten Laborbedingungen verschiedene Pilzstränge kultiviert. Das Pilzmyzel wird in Petrischalen oder Flüssigkulturen vermehrt. Zusätzlich wird eine Pilzstrang-Bibliothek angelegt, um das genetische Material zu bewahren und für zukünftige Vermehrungen zu nutzen.

Das in Phase 1 gezüchtete Pilzmyzel wird auf stark nährstoffreichem Getreide vermehrt. Dies ermöglicht den Pilzen ein exponentielles Wachstum und bereitet sie auf die weitere Entwicklung vor. Die entstandene Pilzbrut dient als Vehikel zur Beimpfung der Substrat-Blöcke.

Während dieser Phase durchwächst das Pilzmyzel die beimpften Substratblöcke. Dies geschieht in speziell klimatisierten Lagerräumen, die auf das optimale Wachstum der Pilze ausgerichtet sind. Zum Ende dieser Phase entwickeln sich Primordien, also kleine Pilzansätze, die den späteren Fruchtkörpern voraus gehen. Die Dauer dieser Phase variiert je nach Pilzart, Strang und Wachstumsbedingungen.



Nachdem das Pilzmyzel erfolgreich die Substrat-Blöcke durchwachsen hat und Primordien ausgebildet wurden, erfolgt der Übergang in die Phase des Fruchtkörperaustriebs. In diesem Schritt werden die Pilz-Blöcke geöffnet und in spezielle Wuchszelte umgelagert. Die Umweltbedingungen in den Zelten werden genau auf die Bedürfnisse der jeweiligen Pilzart abgestimmt, um ein optimales Wachstum und die Entwicklung der Fruchtkörper zu fördern.


Sobald die Pilze in den Wuchszelten erntereif sind, werden die Pilze sorgfältig von Hand geerntet, artgerecht verpackt und für den Vertrieb vorbereitet.
Durch die detaillierte Planung und Strukturierung dieser fünf Phasen ermöglichen wir einen effizienten und kontrollierten Betrieb der Pilzzucht. Die kontinuierliche Überwachung der Umweltbedingungen, die Auswahl hochwertiger Pilzstränge und die optimale Nutzung von Substratblöcken gewährleisten eine erfolgreiche und ertragreiche Pilzproduktion.


Um eine optimale Qualität und Haltbarkeit unserer Nahrungsergänzungsmittel sicherzustellen, werden wir die geernteten Pilze einer Verarbeitungsphase unterziehen müssen. Dabei steht die Trocknung im Mittelpunkt, um die Feuchtigkeit zu reduzieren und die Gefahr von Verderb zu minimieren. In einigen Fällen, je nach Art und Anforderung des Endprodukts, könnte auch eine Pulverisierung der getrockneten Pilze erforderlich sein.